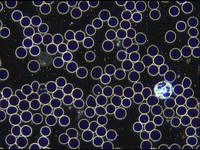
Мікроскопія в темному полі. Як обрати мікроскоп?

Темне поле – це метод спостереження виявленого об'єкта в умовах темного фону. Замість того, щоб пропускати пряме світло через лінзу об'єктива, спочатку дозвольте прямому світлу пройти через конденсор темного поля, а потім змініть шлях таким чином, щоб воно потрапляло на об'єкт навскіс, а відбите або дифраговане світло на поверхні потрапляло в об'єктив, формуючи яскраве зображення на темному фоні. У режимі спостереження мікроскопа темне поле відповідає світлому полю. У темному полі спостерігається дифраговане світлове зображення об'єкта, що досліджується. Це не сам об'єкт, тому можна побачити лише існування та рух об'єкта, але не можна розрізнити його тонку структуру. Але коли об'єкт, що досліджується, є неоднорідним та має довжину хвилі більше 1/2, дифраговане світло на всіх рівнях одночасно потрапляє в об'єктив, і структуру об'єкта можна спостерігати певною мірою. Хоча звичайні темнопольні мікроскопи не можуть чітко побачити тонку структуру об'єктів, вони можуть розрізняти існування та рух частинок розміром понад 0,004 мкм. Це характеристика, якої немає у звичайних мікроскопів (з максимальною роздільною здатністю 0,2 мкм). Структура клітин та рух частинок у клітинах тощо.
Особливості темнопольного мікроскопа
Конденсор темного поля
У темнопольних мікроскопах необхідно використовувати темнопольний конденсор, який спрямовує конус світла від об'єктива. Щоб максимізувати здатність об'єктива збирати розсіяне світло, використовується масляна імерсія, а числова апертура (ЧА) об'єктива повинна бути менше 1,0. Об'єктиви з вищою ЧА можна використовувати, але лише за умови, що вони мають регульовану діафрагму, яка зменшує ЧА. Коли під повністю відкритою діафрагмою апертури вставляється непрозорий світловідбивач типу «павук», центральні світлові промені блокуються, пропускаючи лише периферійні світлові промені через лінзи, утворюючи перевернутий косий порожнистий конус світла без зміни числової апертури. Освітлювальний порожнистий світловий конус утворюється шляхом заломлення світла на периметрі елементів лінзи, де оптична корекція часто найгірша. Незважаючи на це, цей конденсор буде адекватно працювати з об'єктивами з малим збільшенням і дає дуже хороші результати для якісної роботи в темному полі. Для більш точної кількісної мікроскопії необхідно використовувати апланатичні конденсори (скориговані як на хроматичні, так і на сферичні аберації), які працюють набагато краще, створюючи зображення з чіткішими деталями та більш надійними характеристиками.
Об'єктив темного поля
Темнопольний об'єктив — це спеціальний об'єктив, оснащений затемненим круглим кільцем або канавкою (фазовою пластиною), встановленим у склі поблизу задньої фокальної площини об'єктива.
Головною особливістю темнопольного об'єктива є те, що він має порожнистий конусоподібний освітлювальний промінь з великою апертурою. Коли на столику для зразка немає об'єкта, поле зору мікроскопа має бути темним і тьмяним, тому його називають "темнопольним об'єктивом". Коли об'єкт спостереження розміщується на столику для зразка, через розсіювання, заломлення та відбиття освітлювального світла середовищем об'єктива оптичний шлях освітлювального світла змінюється, і частина його розсіюється, заломлюється або відбивається від об'єкта в об'єктив мікроскопа.
Тарілки темного поля
Набір пластин темного поля зовнішнім діаметром 32 мм з павутиною-обмежувачем посередині , можна вставити в конденсор, що легко перетворює його на конденсор темного поля. Діаметр пластини також можна налаштувати для інших мікроскопів.
Як користуватися темнопольним мікроскопом?
Важливі моменти при використанні темнопольного мікроскопа

